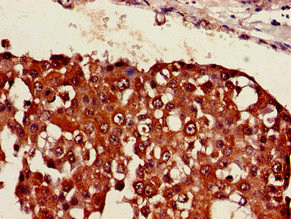

SESN1 Antibody
-
中文名稱:SESN1兔多克隆抗體
-
貨號:CSB-PA021095LA01HU
-
規格:¥440
-
圖片:
-
Western Blot
Positive WB detected in: K562 whole cell lysate, Hela whole cell lysate, NIH/3T3 whole cell lysate
All lanes: SESN1 antibody at 3µg/ml
Secondary
Goat polyclonal to rabbit IgG at 1/50000 dilution
Predicted band size: 57, 64, 50 kDa
Observed band size: 57 kDa -
Immunohistochemistry of paraffin-embedded human breast cancer using CSB-PA021095LA01HU at dilution of 1:100
-
-
其他:
產品詳情
-
產品名稱:Rabbit anti-Homo sapiens (Human) SESN1 Polyclonal antibody
-
Uniprot No.:
-
基因名:
-
別名:1110002G11Rik antibody; AU044290 antibody; MGC118148 antibody; MGC138241 antibody; MGC142129 antibody; OTTMUSP00000022799 antibody; p53 activated gene 26 antibody; p53 regulated PA26 nuclear protein antibody; p53 regulated protein PA26 antibody; p53-regulated protein PA26 antibody; PA26 antibody; RP11-787I22.1 antibody; sesn1 antibody; SESN1_HUMAN antibody; SEST1 antibody; sestrin 1 antibody; Sestrin-1 antibody
-
宿主:Rabbit
-
反應種屬:Human, Mouse
-
免疫原:Recombinant Human Sestrin-1 protein (224-337AA)
-
免疫原種屬:Homo sapiens (Human)
-
標記方式:Non-conjugated
本頁面中的產品,SESN1 Antibody (CSB-PA021095LA01HU),的標記方式是Non-conjugated。對于SESN1 Antibody,我們還提供其他標記。見下表:
-
克隆類型:Polyclonal
-
抗體亞型:IgG
-
純化方式:>95%, Protein G purified
-
濃度:It differs from different batches. Please contact us to confirm it.
-
保存緩沖液:Preservative: 0.03% Proclin 300
Constituents: 50% Glycerol, 0.01M PBS, pH 7.4 -
產品提供形式:Liquid
-
應用范圍:ELISA, WB, IHC
-
推薦稀釋比:
Application Recommended Dilution WB 1:500-1:5000 IHC 1:20-1:200 -
Protocols:
-
儲存條件:Upon receipt, store at -20°C or -80°C. Avoid repeated freeze.
-
貨期:Basically, we can dispatch the products out in 1-3 working days after receiving your orders. Delivery time maybe differs from different purchasing way or location, please kindly consult your local distributors for specific delivery time.
-
用途:For Research Use Only. Not for use in diagnostic or therapeutic procedures.
相關產品
靶點詳情
-
功能:Functions as an intracellular leucine sensor that negatively regulates the TORC1 signaling pathway through the GATOR complex. In absence of leucine, binds the GATOR subcomplex GATOR2 and prevents TORC1 signaling. Binding of leucine to SESN2 disrupts its interaction with GATOR2 thereby activating the TORC1 signaling pathway. This stress-inducible metabolic regulator may also play a role in protection against oxidative and genotoxic stresses. May positively regulate the transcription by NFE2L2 of genes involved in the response to oxidative stress by facilitating the SQSTM1-mediated autophagic degradation of KEAP1. Moreover, may prevent the accumulation of reactive oxygen species (ROS) through the alkylhydroperoxide reductase activity born by the N-terminal domain of the protein. Was originally reported to contribute to oxidative stress resistance by reducing PRDX1. However, this could not be confirmed.
-
基因功能參考文獻:
- Study shows that SESN1 mRNA, UHRF1BP11 mRNA and miRNA-377-3p levels are prognostically relevant in human papillomavirus-negative head and neck squamous cell carcinoma patients. PMID: 28886272
- The antitumor efficacy of pharmacological EZH2 inhibition depends on SESTRIN1, indicating that mTORC1 control is a critical function of EZH2 in lymphoma. PMID: 28659443
- Mass spectrometry analysis, western blot and surface plasmon resonance (SPR) of affinity purified sesn1 and sesn2 proteins confirmed their identity; biophysical characteristics were observed using circular dichroism (CD) showing that sesn1 and sesn2 have a predominant a-helical structure. PMID: 28707664
- this study shows that sestrin1 genetic ablation results in broad reconstitution of immune function in stressed T cells and enhanced vaccine responsiveness in old mice PMID: 28114291
- Rapamycin may prohibit sestrin1 downregulation through targeting mTORC2 in appeasing low shear stress induced EC oxidative apoptosis PMID: 24587596
- PA26 mutations are an infrequent cause of heterotaxia (situs inversus) in humans. PMID: 12607115
- results show that sestrins, a family of proteins whose expression is modulated by p53, are required for regeneration of peroxiredoxins containing Cys-SO(2)H PMID: 15105503
顯示更多
收起更多
-
亞細胞定位:Nucleus. Cytoplasm.
-
蛋白家族:Sestrin family
-
組織特異性:Widely expressed.
-
數據庫鏈接:
Most popular with customers
-
-
YWHAB Recombinant Monoclonal Antibody
Applications: ELISA, WB, IHC, IF, FC
Species Reactivity: Human, Mouse, Rat
-
Phospho-YAP1 (S127) Recombinant Monoclonal Antibody
Applications: ELISA, WB, IHC
Species Reactivity: Human
-
-
-
-
-